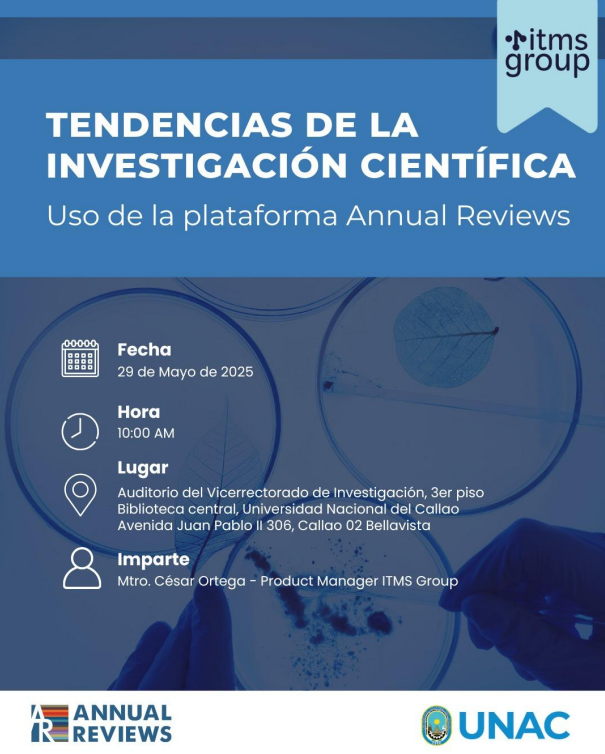

Tendencias de la investigación científica.
Uso de la plataforma Annual Reviews.
Conferencia Presencial “Tendencias de la Investigación Científica”
dirigida a la Comunidad Universitaria.
Jueves 29 de mayo
10:00 a.m.
Ponente: Mtro. César Ortega – Product Manager ITMS Group.


